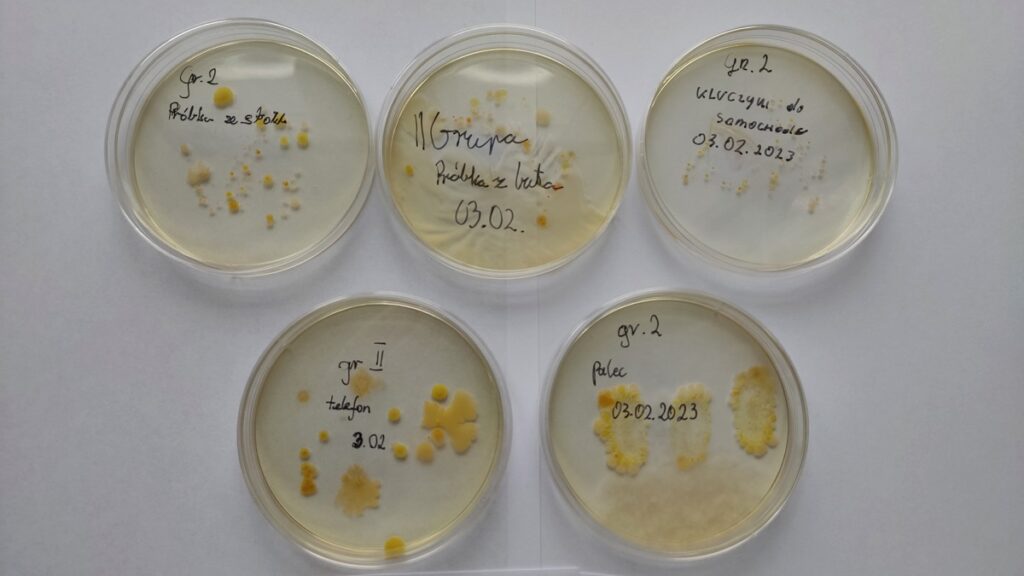
gr. 2

27 lutego 2023 – Warsztaty dla finalistów konkursu
admin 3 lata temu Konkursy , Organizacyjne , OsiągnięciaUczniowie naszej szkoły: Bruno Gleń z kl. III G, Aleksandra Czajka i Sylwia Szlachta z klasy IV Gp – finaliści konkursu „Człowiek w środowisku” zostali zaproszeni na warsztaty do Centrum Innowacyjno-Wdrożeniowego Nowych Technologii w Inżynierii Rolniczej Uniwersytetu Przyrodniczego w Lublinie. Głównym celem zajęć było przygotowanie uczniów do ostatniego etapu konkursu.
Program warsztatów tematycznych dla finalistów konkursu „Człowiek w środowisku”:
- „Fotowoltaika – energia ze słońca” – prowadzący: dr hab. inż. Jacek Kapica, dr inż. Marek Ścibisz;
- „Wykorzystanie biomasy w procesie spalania i fermentacji” – prowadzący: dr hab.inż. Artur Kraszkiewicz, dr hab. inż. Alina Kowalczyk-Juśko;
- „Mikroorganizmy w bioremediacji środowiska” – prowadząca: dr inż. Kamila Rybczyńska-Tkaczyk, dr hab. inż. Justyna Bohacz;
- „Technologie oczyszczania oraz zagospodarowania wód i ścieków” – prowadzący: dr hab. inż. Michał Marzec, dr inż. Agnieszka Listosz, mgr inż. Karolina Jóźwiakowska, prof. dr hab. inż. Tadeusz Siwiec;
- „Procesy zagospodarowania odpadów z przemysłu rolno-spożywczego” – prowadzący: dr inż. Maciej Combrzyński, prof. dr hab. inż. Tomasz Oniszczuk.
W czasie warsztatów uczniowie samodzielnie wykonywali posiewy bakteryjne oraz brali udział w produkcji i degustacji żywności z białka ze świerszczy, zatwierdzonego do spożycia na terenie Europy.
Uczniowie do konkursu przygotowują się pod kierunkiem pani Barbary Zielińskiej.
Życzymy sukcesów!
Podobne artykuły
30 września 2023 – Drużyny na medal
3 lata temu
1 maja 2022 – Złote Szkoły NBP
4 lata temu